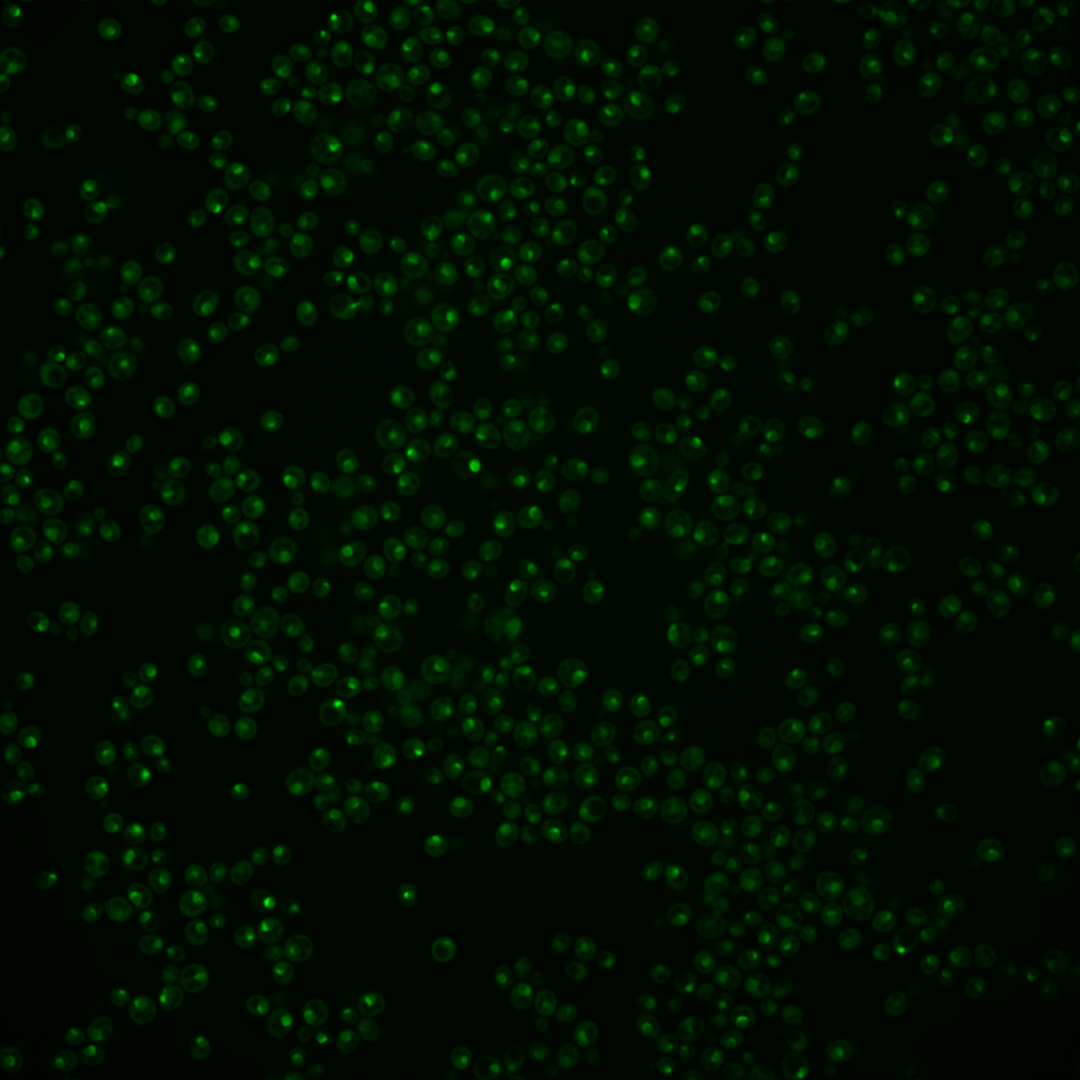
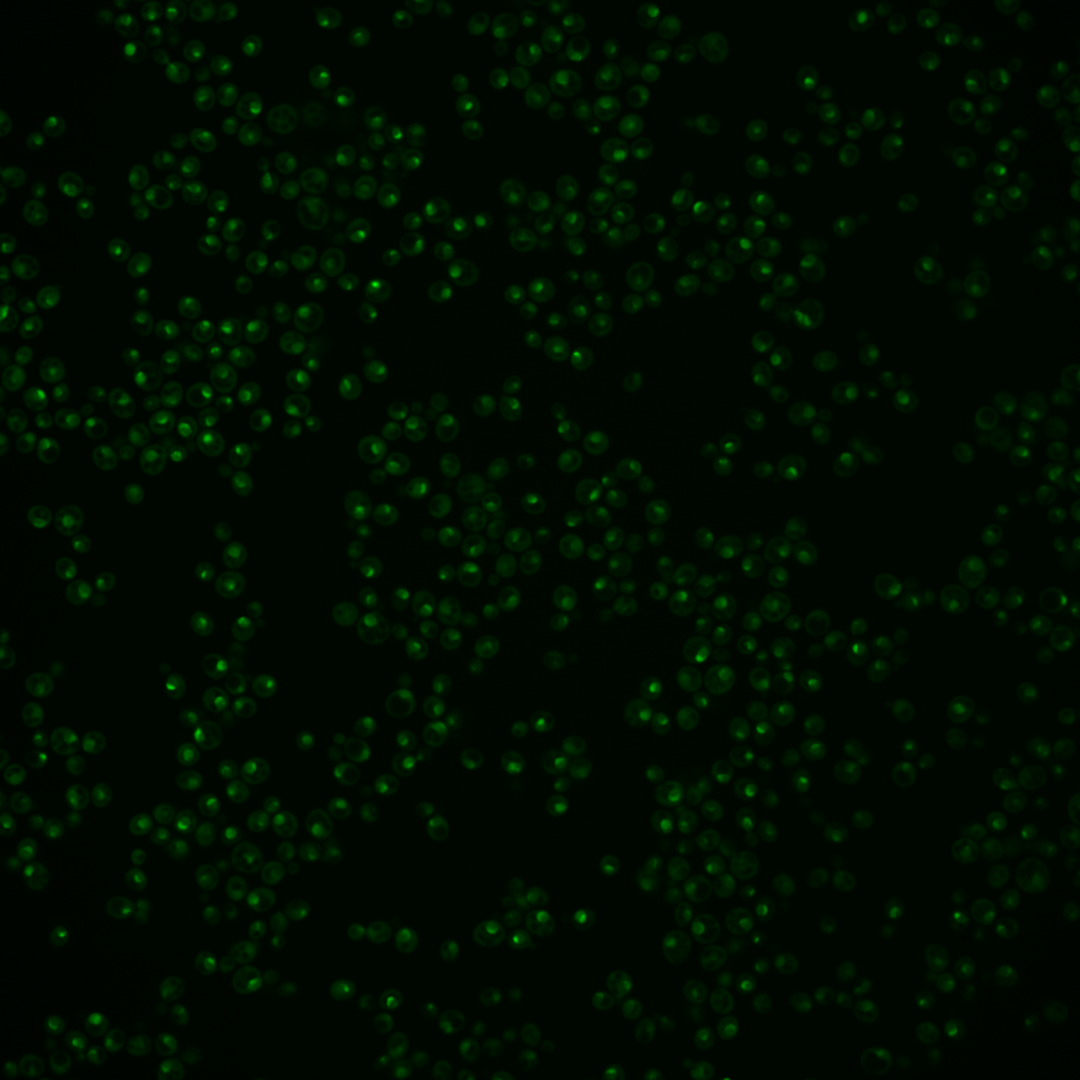

| Standard name | |
|---|---|
| Human Ortholog | |
| Description | Protein associated with U3 and U14 snoRNAs; required for pre-rRNA processing and 40S ribosomal subunit synthesis; localized in the nucleus and concentrated in the nucleolus; human BYSL functionally complements the heat sensitivity of an enp1 ts mutant |
Micrographs




















































































Sub-cellular Localization
Yeast GFP Assignment
Protein Abundance
Localization Change
External localization resources
| ensLOC | DeepLoc | |||||||||||||||||||||||
|---|---|---|---|---|---|---|---|---|---|---|---|---|---|---|---|---|---|---|---|---|---|---|---|---|
| Localization | WT1 | WT2 | WT3 | RAP60 | RAP140 | RAP220 | RAP300 | RAP380 | RAP460 | RAP540 | RAP620 | RAP700 | HU80 | HU120 | HU160 | rpd3Δ_1 | rpd3Δ_2 | rpd3Δ_3 | WT1 | WT2 | WT3 | AF100 | AF140 | AF180 |
| Cortical Patches | 0 | 0 | 0 | 0 | 0 | 0 | 0 | 0 | 0 | 0 | 0 | 0 | 0 | 0 | 0 | 0 | 0 | 0 | 0 | 0 | 0 | 0 | 0 | 0 |
| Bud | 0 | 0 | 0 | 0 | 0 | 0 | 3 | 5 | 1 | 4 | 3 | 5 | 0 | 0 | 0 | 0 | 0 | 0 | 10 | 8 | 3 | 3 | 16 | 16 |
| Bud Neck | 0 | 0 | 0 | 2 | 1 | 2 | 2 | 3 | 1 | 3 | 1 | 1 | 8 | 0 | 1 | 1 | 0 | 0 | 0 | 1 | 0 | 0 | 2 | 4 |
| Bud Site | 0 | 0 | 0 | 0 | 0 | 8 | 4 | 14 | 3 | 8 | 10 | 16 | 0 | 0 | 1 | 1 | 0 | 0 | – | – | – | – | – | – |
| Cell Periphery | 0 | 0 | 0 | 0 | 0 | 0 | 0 | 0 | 0 | 0 | 0 | 0 | 0 | 0 | 0 | 1 | 0 | 0 | 0 | 0 | 0 | 0 | 0 | 0 |
| Cytoplasm | 8 | 5 | 5 | 6 | 8 | 10 | 15 | 8 | 7 | 3 | 4 | 6 | 25 | 50 | 68 | 15 | 10 | 3 | 2 | 1 | 0 | 0 | 2 | 4 |
| Endoplasmic Reticulum | 0 | 0 | 0 | 0 | 0 | 0 | 0 | 0 | 0 | 0 | 0 | 0 | 0 | 0 | 0 | 1 | 3 | 0 | 0 | 0 | 0 | 0 | 1 | 0 |
| Endosome | 11 | 2 | 6 | 12 | 6 | 4 | 17 | 25 | 2 | 11 | 8 | 9 | 18 | 5 | 13 | 10 | 7 | 0 | 17 | 3 | 10 | 14 | 38 | 47 |
| Golgi | 0 | 0 | 0 | 0 | 0 | 0 | 1 | 0 | 1 | 0 | 0 | 0 | 0 | 0 | 0 | 0 | 2 | 2 | 0 | 1 | 0 | 0 | 0 | 0 |
| Mitochondria | 13 | 2 | 4 | 15 | 15 | 50 | 72 | 107 | 56 | 91 | 82 | 113 | 9 | 21 | 28 | 30 | 10 | 10 | 1 | 0 | 1 | 0 | 1 | 1 |
| Nucleus | 50 | 12 | 3 | 14 | 23 | 28 | 39 | 49 | 22 | 45 | 37 | 36 | 25 | 30 | 40 | 25 | 14 | 19 | 71 | 33 | 13 | 26 | 23 | 12 |
| Nuclear Periphery | 0 | 0 | 0 | 1 | 1 | 1 | 0 | 0 | 2 | 3 | 3 | 3 | 0 | 0 | 1 | 0 | 0 | 0 | 2 | 0 | 0 | 1 | 1 | 3 |
| Nucleolus | 151 | 65 | 47 | 138 | 179 | 182 | 223 | 331 | 140 | 202 | 171 | 210 | 210 | 406 | 420 | 180 | 101 | 75 | 178 | 76 | 48 | 95 | 152 | 165 |
| Peroxisomes | 0 | 0 | 1 | 0 | 0 | 3 | 1 | 5 | 1 | 1 | 1 | 0 | 1 | 3 | 7 | 3 | 3 | 0 | 1 | 0 | 0 | 0 | 0 | 0 |
| SpindlePole | 1 | 0 | 1 | 13 | 16 | 24 | 41 | 68 | 11 | 29 | 32 | 23 | 6 | 32 | 43 | 1 | 2 | 0 | 34 | 12 | 12 | 43 | 93 | 79 |
| Vac/Vac Membrane | 67 | 48 | 20 | 1 | 1 | 4 | 5 | 6 | 2 | 1 | 1 | 4 | 7 | 4 | 4 | 18 | 9 | 6 | 8 | 7 | 10 | 5 | 14 | 22 |
| Unique Cell Count | 261 | 118 | 74 | 156 | 207 | 234 | 301 | 438 | 187 | 268 | 242 | 290 | 262 | 482 | 537 | 239 | 136 | 101 | 331 | 147 | 106 | 196 | 357 | 372 |
| Labelled Cell Count | 301 | 134 | 87 | 202 | 250 | 316 | 423 | 621 | 249 | 401 | 353 | 426 | 309 | 551 | 626 | 286 | 161 | 115 | 331 | 147 | 106 | 196 | 357 | 372 |
Yeast GFP Assignment
Protein Abundance
| Screen | WT1 | WT2 | WT3 | RAP60 | RAP140 | RAP220 | RAP300 | RAP380 | RAP460 | RAP540 | RAP620 | RAP700 | HU80 | HU120 | HU160 | rpd3Δ_1 | rpd3Δ_2 | rpd3Δ_3 | AF100 | AF140 | AF180 |
|---|---|---|---|---|---|---|---|---|---|---|---|---|---|---|---|---|---|---|---|---|---|
| Mean Cell GFP Intensity (1e-4) | 12.9 | 14.9 | 11.6 | 13.6 | 11.3 | 9.2 | 7.5 | 7.5 | 7.2 | 6.6 | 6.9 | 6.7 | 15.3 | 15.5 | 14.3 | 19.7 | 22.3 | 24.7 | 15.3 | 14.1 | 15.5 |
| Std Deviation (1e-4) | 2.6 | 3.1 | 2.8 | 4.2 | 3.2 | 2.5 | 2.4 | 2.0 | 2.1 | 1.8 | 2.0 | 2.0 | 4.4 | 6.3 | 6.8 | 6.4 | 7.6 | 7.6 | 2.6 | 3.2 | 2.9 |
| Intensity Change (Log2) | – | – | – | 0.23 | -0.04 | -0.33 | -0.64 | -0.63 | -0.68 | -0.82 | -0.76 | -0.79 | 0.39 | 0.41 | 0.3 | 0.76 | 0.94 | 1.09 | 0.39 | 0.28 | 0.42 |
Localization Change
| Localization | RAP60 | RAP140 | RAP220 | RAP300 | RAP380 | RAP460 | RAP540 | RAP620 | RAP700 | HU80 | HU120 | HU160 | rpd3Δ_1 | rpd3Δ_2 | rpd3Δ_3 |
|---|---|---|---|---|---|---|---|---|---|---|---|---|---|---|---|
| Cortical Patches | 0 | 0 | 0 | 0 | 0 | 0 | 0 | 0 | 0 | 0 | 0 | 0 | 0 | 0 | 0 |
| Bud | 0 | 0 | 0 | 0 | 0 | 0 | 0 | 0 | 0 | 0 | 0 | 0 | 0 | 0 | 0 |
| Bud Neck | 0 | 0 | 0 | 0 | 0 | 0 | 0 | 0 | 0 | 0 | 0 | 0 | 0 | 0 | 0 |
| Bud Site | 0 | 0 | 0 | 0 | 0 | 0 | 0 | 0 | 0 | 0 | 0 | 0 | 0 | 0 | 0 |
| Cell Periphery | 0 | 0 | 0 | 0 | 0 | 0 | 0 | 0 | 0 | 0 | 0 | 0 | 0 | 0 | 0 |
| Cytoplasm | 0 | 0 | 0 | 0 | 0 | 0 | 0 | 0 | 0 | 0.7 | 1.0 | 1.5 | 0 | 0.2 | 0 |
| Endoplasmic Reticulum | 0 | 0 | 0 | 0 | 0 | 0 | 0 | 0 | 0 | 0 | 0 | 0 | 0 | 0 | 0 |
| Endosome | -0.1 | 0 | 0 | 0 | 0 | 0 | 0 | 0 | 0 | -0.4 | 0 | 0 | 0 | 0 | 0 |
| Golgi | 0 | 0 | 0 | 0 | 0 | 0 | 0 | 0 | 0 | 0 | 0 | 0 | 0 | 0 | 0 |
| Mitochondria | 1.1 | 0.5 | 3.1 | 3.5 | 3.7 | 4.2 | 4.9 | 4.8 | 5.5 | 0 | 0 | 0 | 1.7 | 0 | 1.1 |
| Nucleus | 1.3 | 1.8 | 2.0 | 2.2 | 1.9 | 1.9 | 2.8 | 2.5 | 2.1 | 1.5 | 0 | 1.1 | 1.7 | 1.6 | 2.9 |
| Nuclear Periphery | 0 | 0 | 0 | 0 | 0 | 0 | 0 | 0 | 0 | 0 | 0 | 0 | 0 | 0 | 0 |
| Nucleolus | 4.5 | 4.3 | 2.4 | 1.8 | 2.2 | 1.8 | 2.0 | 1.2 | 1.5 | 3.0 | 4.3 | 2.8 | 2.0 | 1.6 | 1.5 |
| Peroxisomes | 0 | 0 | 0 | 0 | 0 | 0 | 0 | 0 | 0 | 0 | 0 | 0 | 0 | 0 | 0 |
| SpindlePole | 0 | 0 | 2.4 | 3.0 | 3.3 | 0 | 2.5 | 2.9 | 0 | 0 | 0 | 2.1 | 0 | 0 | 0 |
| Vacuole | -6.5 | -7.5 | -7.1 | 0 | 0 | -6.8 | 0 | 0 | 0 | -6.8 | 0 | 0 | -4.5 | -4.1 | -3.9 |
External localization resources
Images






























Protein Concentration and Protein Localization Data
| R1 | R2 | R3 | ||||||||||||||||
|---|---|---|---|---|---|---|---|---|---|---|---|---|---|---|---|---|---|---|
| G1 Pre-START | G1 Post-START | S/G2 | Metaphase | Anaphase | Telophase | G1 Pre-START | G1 Post-START | S/G2 | Metaphase | Anaphase | Telophase | G1 Pre-START | G1 Post-START | S/G2 | Metaphase | Anaphase | Telophase | |
| Concentration | 9.0149 | 11.5901 | 9.8701 | 10.0181 | 8.7015 | 9.9735 | 9.1217 | 12.112 | 10.7979 | 8.8997 | 9.9743 | 10.85 | 10.9788 | 14.4926 | 12.815 | 12.2004 | 11.919 | 12.562 |
| Actin | 0.0089 | 0.0003 | 0 | 0.0001 | 0.0011 | 0.0005 | 0.0195 | 0 | 0.0037 | 0.0008 | 0.0046 | 0.0027 | 0.0286 | 0 | 0.0033 | 0.028 | 0.0052 | 0.0008 |
| Bud | 0.0007 | 0.0001 | 0.0002 | 0.0003 | 0.0003 | 0.0002 | 0.0006 | 0.0002 | 0.0002 | 0.001 | 0.0002 | 0.0004 | 0.0003 | 0.0002 | 0.0002 | 0.0003 | 0.0006 | 0.0001 |
| Bud Neck | 0.0039 | 0.0016 | 0.002 | 0.0021 | 0.0026 | 0.0042 | 0.0035 | 0.0027 | 0.0106 | 0.0066 | 0.0051 | 0.0064 | 0.0029 | 0.0038 | 0.0025 | 0.0066 | 0.0028 | 0.0083 |
| Bud Periphery | 0.0013 | 0.0001 | 0.0003 | 0.0003 | 0.0006 | 0.0007 | 0.0011 | 0.0001 | 0.0003 | 0.0015 | 0.0004 | 0.0007 | 0.0005 | 0.0002 | 0.0003 | 0.0005 | 0.0008 | 0.0003 |
| Bud Site | 0.0037 | 0.0011 | 0.0031 | 0.0011 | 0.0013 | 0.0009 | 0.0042 | 0.0031 | 0.003 | 0.0079 | 0.002 | 0.0019 | 0.0031 | 0.0056 | 0.0021 | 0.0023 | 0.0047 | 0.001 |
| Cell Periphery | 0.0005 | 0.0002 | 0.0005 | 0.0004 | 0.0006 | 0.0004 | 0.0011 | 0.0003 | 0.0009 | 0.0012 | 0.0004 | 0.0004 | 0.0004 | 0.0006 | 0.0006 | 0.0011 | 0.0004 | 0.0005 |
| Cytoplasm | 0.0068 | 0.0007 | 0.0003 | 0.0074 | 0.0007 | 0.0002 | 0.0216 | 0.0019 | 0.0007 | 0.0037 | 0.0322 | 0.0023 | 0.0061 | 0.0169 | 0.0012 | 0.0005 | 0.0082 | 0.0003 |
| Cytoplasmic Foci | 0.0095 | 0.0027 | 0.001 | 0.0018 | 0.0032 | 0.0019 | 0.0223 | 0.0022 | 0.0225 | 0.0117 | 0.024 | 0.0104 | 0.0183 | 0.0045 | 0.0058 | 0.003 | 0.03 | 0.0036 |
| Eisosomes | 0.0001 | 0 | 0 | 0 | 0.0002 | 0 | 0.0002 | 0 | 0 | 0.0001 | 0.0001 | 0 | 0.0003 | 0 | 0.0001 | 0.0001 | 0.0001 | 0 |
| Endoplasmic Reticulum | 0.0037 | 0.0001 | 0.0001 | 0.0008 | 0.0003 | 0.0003 | 0.0037 | 0.0004 | 0.0002 | 0.0012 | 0.0035 | 0.0006 | 0.0029 | 0.0001 | 0.0016 | 0.0001 | 0.0018 | 0.0001 |
| Endosome | 0.015 | 0.001 | 0.0007 | 0.0086 | 0.0051 | 0.0043 | 0.0332 | 0.0033 | 0.0115 | 0.01 | 0.0126 | 0.0059 | 0.0139 | 0.0026 | 0.0115 | 0.0026 | 0.0243 | 0.002 |
| Golgi | 0.0037 | 0.0004 | 0.0002 | 0.0004 | 0.0013 | 0.0065 | 0.0149 | 0.0002 | 0.0037 | 0.0022 | 0.0034 | 0.0023 | 0.0067 | 0.0005 | 0.0075 | 0.0021 | 0.0202 | 0.0023 |
| Lipid Particles | 0.0101 | 0.004 | 0.0031 | 0.0033 | 0.0094 | 0.0064 | 0.0258 | 0.0021 | 0.0159 | 0.0461 | 0.0123 | 0.0058 | 0.0241 | 0.0042 | 0.0122 | 0.0115 | 0.032 | 0.0078 |
| Mitochondria | 0.0042 | 0.0019 | 0.0002 | 0.0006 | 0.1027 | 0.0133 | 0.0062 | 0.0001 | 0.0004 | 0.005 | 0.0678 | 0.0081 | 0.0035 | 0.0001 | 0.0031 | 0.0005 | 0.0271 | 0.0005 |
| None | 0.0023 | 0.0004 | 0 | 0.0003 | 0.0003 | 0.0001 | 0.0036 | 0.0001 | 0.0004 | 0.0016 | 0.0059 | 0.0004 | 0.0103 | 0.0001 | 0.0003 | 0.0001 | 0.0012 | 0 |
| Nuclear Periphery | 0.0105 | 0.0009 | 0.0007 | 0.0089 | 0.0043 | 0.0058 | 0.0316 | 0.0037 | 0.0003 | 0.0096 | 0.0214 | 0.0079 | 0.014 | 0.0005 | 0.005 | 0.0016 | 0.0039 | 0.0029 |
| Nucleolus | 0.6573 | 0.7943 | 0.8273 | 0.6179 | 0.6315 | 0.7345 | 0.5053 | 0.7073 | 0.8172 | 0.703 | 0.5764 | 0.6938 | 0.6092 | 0.7387 | 0.7878 | 0.6773 | 0.5556 | 0.7046 |
| Nucleus | 0.2144 | 0.1705 | 0.1463 | 0.3243 | 0.182 | 0.1945 | 0.2242 | 0.2475 | 0.0923 | 0.1256 | 0.163 | 0.2168 | 0.2055 | 0.21 | 0.1439 | 0.2412 | 0.2472 | 0.2351 |
| Peroxisomes | 0.005 | 0.0011 | 0.0001 | 0.0002 | 0.0012 | 0.0075 | 0.013 | 0.0001 | 0.0038 | 0.0012 | 0.0035 | 0.0036 | 0.0059 | 0.0002 | 0.0012 | 0.0012 | 0.0113 | 0.0006 |
| Punctate Nuclear | 0.0327 | 0.0176 | 0.0087 | 0.0106 | 0.0395 | 0.0128 | 0.0465 | 0.0213 | 0.0067 | 0.0338 | 0.0587 | 0.0268 | 0.0369 | 0.0068 | 0.0052 | 0.0121 | 0.0161 | 0.0265 |
| Vacuole | 0.0041 | 0.0008 | 0.0046 | 0.0088 | 0.0094 | 0.0033 | 0.015 | 0.0031 | 0.0052 | 0.0211 | 0.0018 | 0.0024 | 0.0043 | 0.0041 | 0.0039 | 0.007 | 0.0034 | 0.0023 |
| Vacuole Periphery | 0.0015 | 0.0002 | 0.0005 | 0.0017 | 0.0025 | 0.0018 | 0.0031 | 0.0002 | 0.0003 | 0.0053 | 0.0006 | 0.0004 | 0.0023 | 0.0002 | 0.0006 | 0.0004 | 0.003 | 0.0002 |
Sequencing Data
| R1 | R2 | |||||||||
|---|---|---|---|---|---|---|---|---|---|---|
| G1 Post-START | S/G2 | Metaphase | Anaphase | Telophase | G1 Post-START | S/G2 | Metaphase | Anaphase | Telophase | |
| Gene Expression | 62.3135 | 60.4597 | 53.9373 | 39.0858 | 45.3224 | 43.2915 | 41.3834 | 37.5504 | 28.5546 | 46.9461 |
| Translational Efficiency | 1.8041 | 1.8205 | 1.7687 | 1.7739 | 1.7786 | 1.5339 | 1.8361 | 1.2346 | 1.5073 | 1.4443 |
Hit Data
| Dataset | Hit |
|---|---|
| Protein Concentration | ✘ |
| Protein Localization | ✘ |
| Gene Expression | ✔ |
| Translational Efficiency | ✘ |
Endocytosis
| Temp | Actin Patch (Sac6-tdTomato) | Cortical Patch (Sla1-GFP) | Late Endosome (Snf7-GFP) | Vacuole (Vph1-GFP) |
|---|---|---|---|---|
| 37℃ | ||||
| RT |
Cell Cycle Omics
CYCLoPs (Enp1-GFP)
| Gene / Allele | Actin Patch (Sac6-tdTomato) | Cortical Patch (Sla1-GFP) | Late Endosome (Snf7-GFP) | Vacuole (Sac6-tdTomato) |
|---|
| Gene | Images |
|---|
| Gene | Images |
|---|
Images are not yet available
Images are not yet available